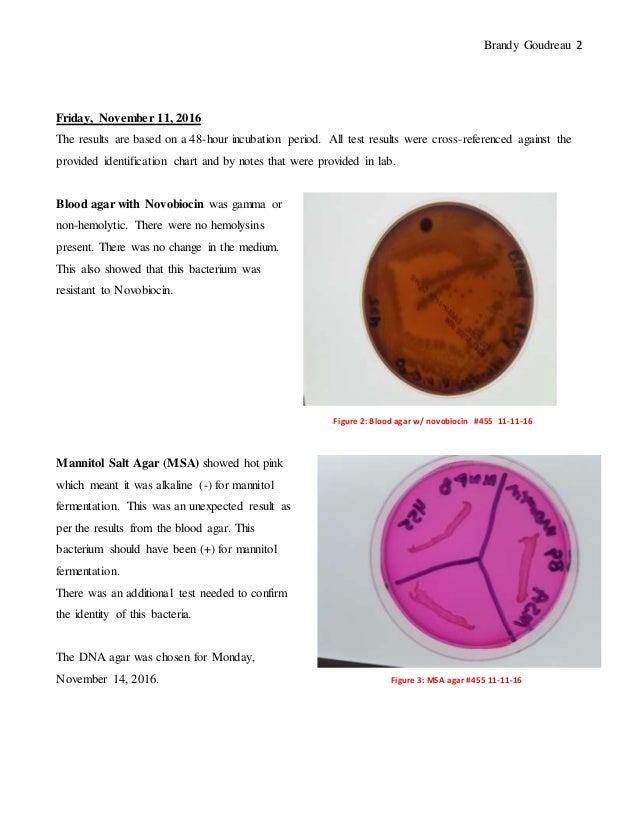

Msa Positive Test

Best Lab Exam Practice Flashcards Quizlet

Microbiology Lab Molb 2210

Mannitol Salt Agar Test

Biochemical Test And Identification Of Salmonella Typhi

Mwzz6xdn99okum

Staphylococcus Gram Cocci In Clumps Ppt Video Online Download

3

Biol 230 Lab Manual Lab 15

9o2pcfm Dur 8m

Study Exercise 51 Staphylococci Flashcards Quizlet

Mannitol Salt Agar For The Isolation Of Staphylococcus Aureus

Biochemical Test And Identification Of Enterococcus Faecalis

Metabolism Physiology And Growth Characteristics Of Cocci Microbiology A Laboratory Experience

Growth Of Staphylococcus Sp On Mannitol Salt Agar Slant The Organisms Download Scientific Diagram

Mannitol Salt Agar Msa Composition Uses And Colony Characteristics Learn Microbiology Online

B Cereus Cudmore Lewis Microbewiki
Q Tbn 3aand9gcq1d7hg4azo7wdzwbrpugcgxr3hzi05irgmcidtbjrvj0afxub2 Usqp Cau
1

Welcome To Microbugz Blood Agar Test

Differential And Selective Bacterial Growth Media Page 2

Mannitol Salt Agar Msa Test Scientist Cindy

Staphylococcus Aureus And Staphylococcus Epidermidis On Mannitol Salt Agar Mannitol Salt Agar Composition Positive And Negative Result On Mannitol Salt Agar

Harpactirinae Biotechnology Microbes Theoretical Result Part 2

Mannitol Salt Agar Msa Plate

Mannitol Salt Agar Msa Test Scientist Cindy

Bam Chapter 14 Bacillus Cereus Fda

Skills In Medical Microbiology

Vetbact

Pseudomonas Aeruginosa Morphology Growth Characteristics And Microscopic Appearance Of P Aerginosa Images Of Pseudomonas Aeruginosa Infections Caused By Pseudomonas Aeruginosa

Gram Positive Sphere Unknown Msa Mannitol Salt Agar Plate Flashcards Quizlet

A Dream Within A Dream Mannitol Salt Agar Test For Bacillus Subtilis

Welcome To Microbugz Macconkey Agar

You Have An Unknown Bacterium You Decide To Plate It On An Msa Blate After 24 Homeworklib

Vetbact

Bio Sci M122 Lecture 42 Selective And Differental Media Oneclass

Isolation And Identification Of Gram Positive Cocci Ppt Video Online Download

Kankakee Msa Covid 19 Response Recovery Community Health Information Kankakee County

Mannitol Salt Agar Msa Test Scientist Cindy
Brandy Goudreau Unknown Project Positive

Microbiology Lab Molb 2210

Mannitol Salt Agar Msa Agar Petri Stock Photo Edit Now
Http Www Interchim Fr Ft J Jh992a Pdf

Biochemical Test

Asmscience Mannitol Salt Agar Plates Protocols

Prevalence Of Methicillin Resistant Staphylococcus Aureus In Shrines

Ppt Isolation Identification Of Staphylococci Powerpoint Presentation Id

Mannitol Salt Agar Msa Youtube
Link Springer Com Content Pdf 10 1007 S 012 11 5 Pdf

Metabolism Physiology And Growth Characteristics Of Cocci Microbiology A Laboratory Experience

Mannitol Salt Agar Wikipedia

Biotyping And Susceptibility Test Algorithm For S Aureus Msa Manitol Download Scientific Diagram
1

Identifying Unknown Bacteria Lab

Solved 1 Zone A Is Msa Negative If Bacteria Is Still Ca Chegg Com

Pdf Identification Of Staphylococcus Aureus Dnase And Mannitol Salt Agar Improve The Efficiency Of The Tube Coagulase Test

6 3c Selective And Differential Media Biology Libretexts

Deoxyribonuclease Dnase Test Principle Procedure And Results Learn Microbiology Online

Mannitol Salt Agar Msa Composition Uses And Colony Characteristics Learn Microbiology Online

Mannitol Salt Agar Msa Plate

Salt Tolerance Test Biochemical Test Microbe Notes
Www Studocu Com En Us Document College Of Marin Kentfield Microbiology Summaries Microbio Lab Exam 2 Review View
Www Jfmed Uniba Sk Fileadmin Jlf Pracoviska Ustav Mikrobiologie A Imunologie Vla Staphylococci Pdf

Klebsiella Pneumoniae Colony Morphology And Microscopic Appearance Basic Characteristic And Tests For Identification Of Klebsiella Pneumoniae Bacteria Images Of K Pneumoniae Klebsiella Peumoniae Treatment And Antibiotics Used For K Pneumoniae

Mannitol Salt Bacterial Growth Medium Msa

Lab Packet 3 Doc Maria Martinez Gram Catalase Positive Test Id Ex Ex Antibiotic Mannitol Blood Snyder Agar Test Salts Susceptibility Ex Agar Msa Ex Ex Course Hero

Media Used For Bacterial Growth Microbiology

Mannitol Salt Agar Msa Composition Uses And Colony Characteristics Learn Microbiology Online

Msa Emb Mac Media Youtube

Mannitol Salt Agar Nitrate Nitrite

Mannitol Salt Agar Plate Test Composition Preparation Uses Laboratoryinfo Com

Print Microbiology Lab Practical Flashcards Easy Notecards

Solved Microbiology I Have To Identify Which Bacteria Is Chegg Com

How To Interpret Mannitol Salt Agar Bacterial Growth Medium Youtube

Streak Unknown Mixture For Isolation And Perform Gram Stain By Megan Alix

Microbiology Lab Molb 2210

Mannitol Salt Agar Plate Test Composition Preparation Uses Laboratoryinfo Com

Screening Method For I Xmlns Staphylococcus Aureus I Identification In Subclinical Bovine Mastitis From Dairy Farms

Microbiology Lab Molb 2210

Macconkey Agar Wikipedia

Tests Used For Gram Positive And Negative Bacteria Medical Laboratory Technician Medical Laboratory Science Microbiology Lab

Solved An Unknown Specimen Was Grown On Mannitol Salt Aga Chegg Com

Microbio 225 Lab Test 3 Selective And Differential Media Imvic Biochem Tests With Some Bacterial Samples Flashcards Questions And Answers Quizlet

Staphylococcus Classification Online Presentation

Solved Test Results For Isolate 1 Msa Plate Glucose Br Chegg Com

Microbio 225 Lab Test 3 Selective And Differential Media Imvic Biochem Tests With Some Bacterial Samples Flashcards Questions And Answers Quizlet

Lab 5 Integumentary System Bacteriology And Identification Ppt Download

Uscg Safety Advisory 01 Mid Atlantic Maritime Academy

Mannitol Salt Agar Msa For The Identification Of Staphylococcus Aureus And Epidermidis

Mannitol Salt Agar Msa Test Superfarmer S Weblog

Macconkey Agar Youtube

Lab Practical Two Flashcards Quizlet

Summary Of Biochemical Tests In Microbiology Ppt Video Online Download
Physiological Tests

Mannitol Salt Agar Msa Test Scientist Cindy

Biochemical Test And Identification Of Bacillus Subtilis

Causative Agent Bi 3 Medical Microbiology

Mannitol Salt Agar Plate Test Composition Preparation Uses Laboratoryinfo Com

Pathogenic Bacteria And Identification Microbiology Learning The Why Ology Of Microbial Testing

Staphylococcus Identification Tests Ppt Video Online Download

Solved Tests Carbohydrate Metabolism Glucose Fermentatio Chegg Com

Mannitol Salt Agar Msa Results Theory Youtube

Solved The Figure Below Shows Positive And Negative Resul Chegg Com
Http Www Interchim Fr Ft J Jh992a Pdf

Welcome To Microbugz Mannitol Salt Agar



